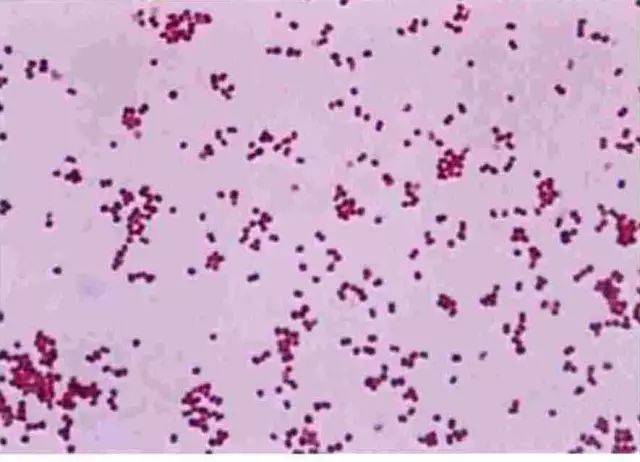

脑膜炎奈瑟菌图片

微生物脑膜炎奈瑟氏菌的颅内感染病例
图片尺寸922x676
微生物脑膜炎奈瑟氏菌的颅内感染病例
图片尺寸1077x685
脑膜炎应该全面防治
图片尺寸500x375
微生物脑膜炎奈瑟氏菌的颅内感染病例
图片尺寸1011x675
脑膜炎奈瑟菌肺炎具有传染性,免疫力低下的人群容易受到感染
图片尺寸1000x751菌脑膜炎奈瑟氏菌
图片尺寸1200x800
了一个熟悉的诱发脑膜炎的病因——一种名为w群脑膜炎奈瑟菌的细菌
图片尺寸640x462
【引用】【分享】eqa-1101号标本细菌分离鉴定过程(脑膜炎奈瑟菌)
图片尺寸2048x1536
脑膜炎奈瑟菌
图片尺寸1080x810
脑膜炎奈瑟菌
图片尺寸460x366
脑膜炎奈瑟菌
图片尺寸2000x2667
微生物脑膜炎奈瑟氏菌的颅内感染病例
图片尺寸1215x692
借助扫描电子显微镜拍摄的脑膜炎奈瑟氏菌,可引发流行性脑脊髓膜炎
图片尺寸551x446
球菌 (coccus) 双球菌(diplococcus) 双球菌 脑膜炎奈瑟菌 肺炎链球菌
图片尺寸1080x810
脑膜炎球菌(meningococcus)的学名是脑膜炎奈瑟氏球菌(n.
图片尺寸300x240
脑膜炎奈瑟菌的那些事儿
图片尺寸728x683
脑膜炎奈瑟菌的那些事儿
图片尺寸740x737p>脑膜炎奈瑟菌(n.
图片尺寸500x594
脑膜炎奈瑟菌的传播
图片尺寸1023x640
脑膜炎奈瑟菌的实验室检测之旅
图片尺寸551x512
猜你喜欢:淋病奈瑟菌图片脑膜炎奈瑟菌手绘图脑膜炎奈瑟菌淋病奈瑟菌手绘图脑膜炎奈瑟菌绘图脑膜炎奈瑟菌镜下图片脑膜炎奈瑟菌培养脑膜炎球菌图片脑膜炎奈瑟菌症状脑膜炎奈瑟菌排列脑膜炎奈瑟菌红蓝脑膜炎奈瑟菌平板脑膜炎双球菌图片脑膜炎奈瑟菌显微镜脑膜炎球菌图片手绘图脑膜炎奈瑟菌培养基奈瑟菌图片脑膜炎奈瑟菌革兰染色淋病奈瑟菌图片手绘图脑膜炎球菌绘图脑膜炎图片脑膜炎球菌手绘图脑膜炎球菌脑膜炎患者图片脑膜炎卡通图片儿童脑膜炎图片脑膜炎双球菌手绘图脑膜炎双球菌隐球菌脑膜炎淋病奈瑟菌节约用纸图片厕所孙艺萌芭蕾舞oliviawilde靓仔背影编程代码大全上新了故宫佟丽娅梅花三弄谱子古琴大花圈样式遇龙15集预告5.3天天练答案图片语文百里骨科约策不良人图标超清图片